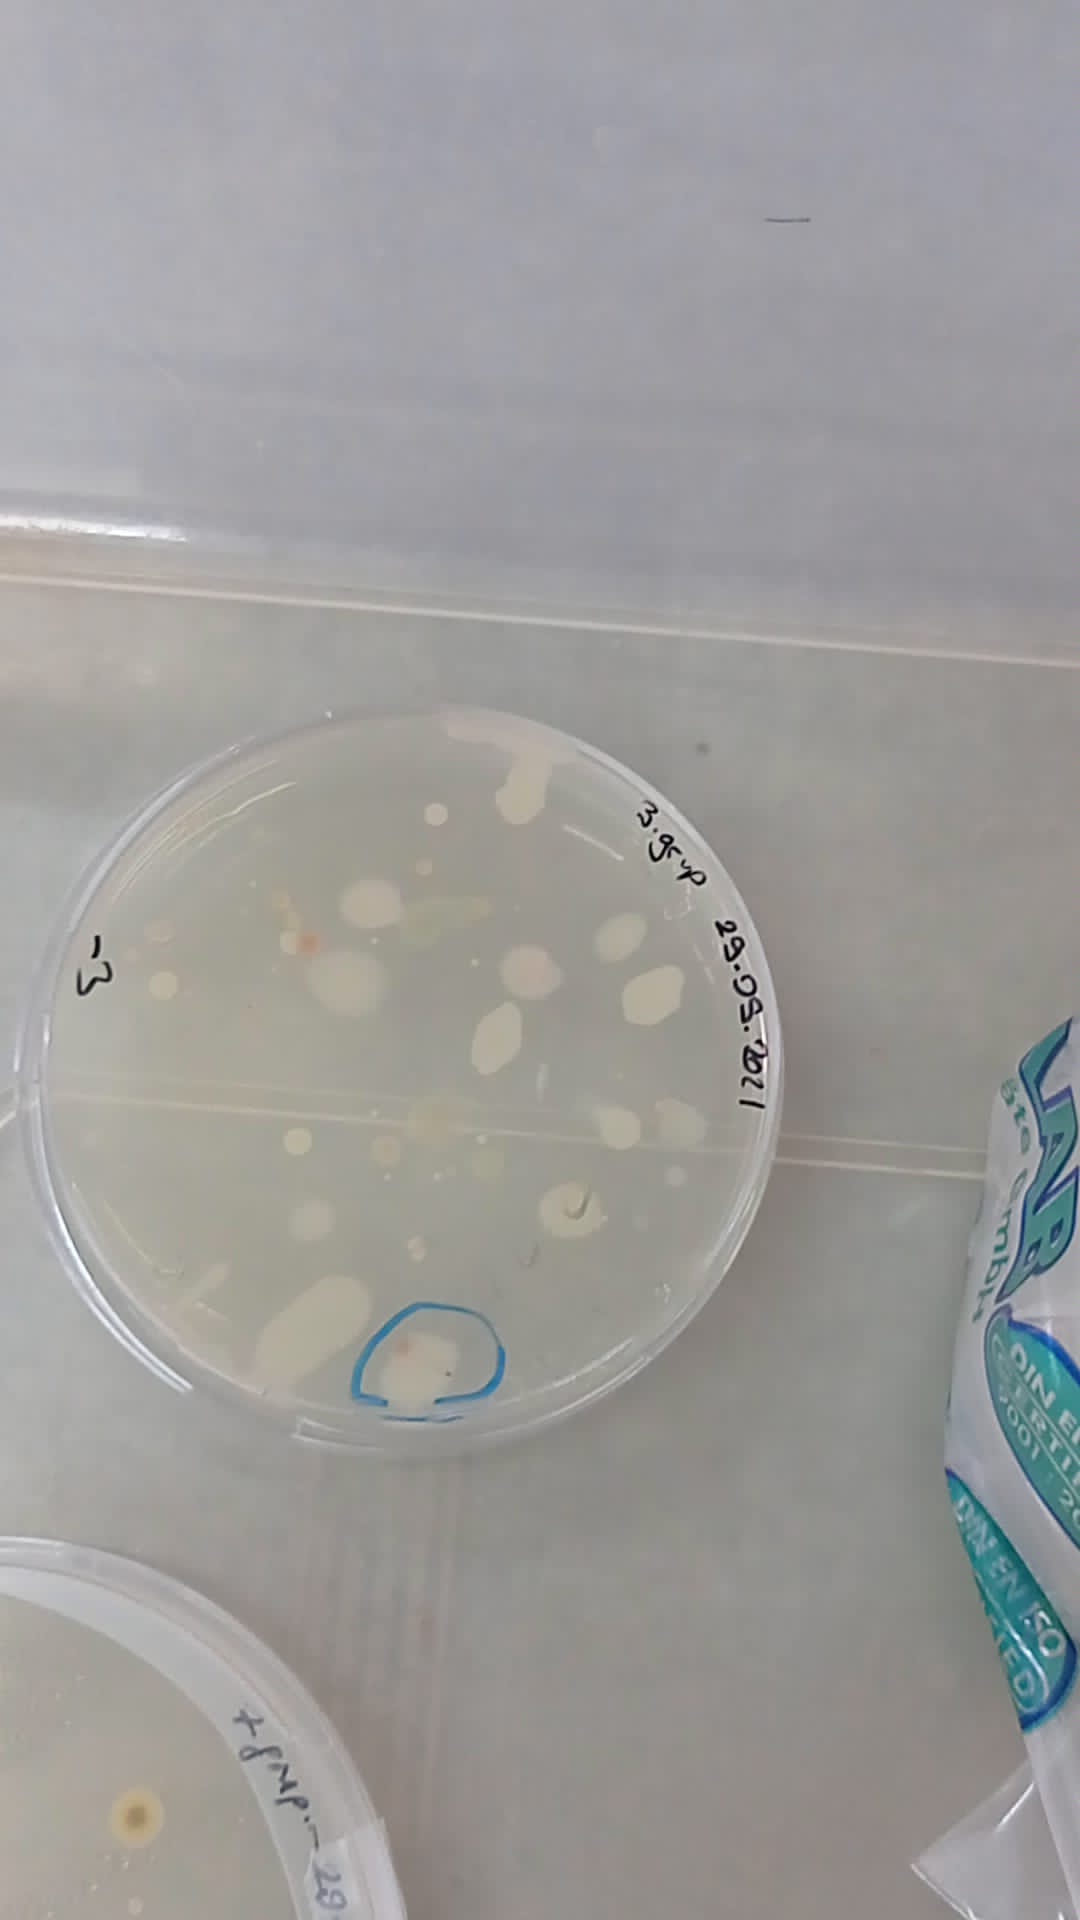

TIBBİ VE AROMATİK BİTKİLER PROGRAMI ÖĞRENCİLERİ ANTALYA'DA TEKNİK GEZİYE KATILDI
20.10.2021 tarihinde Yüksekokulumuz Tıbbi ve Aromatik Bitkiler Programı 2. sınıf öğrencilerimiz program öğretim görevlilerimiz eşliğinde Akdeniz Üniversitesi Ziraat Fakültesi Bahçe Bitkileri ile Toprak Bilimi ve Bitki Besleme Laboratuvarlarına ziyarette bulunmuşlardır. Laboratuvar görevlileri tarafından sırasıyla 'kontrollü atmosferde meyve ve sebzelerin depolanması' ile 'toprak-bitki analizlerinin esasları' hakkında bilgiler aktarılmıştır. Daha sonra, Batı Akdeniz Tarımsal Araştırma Enstitüsü (BATEM) Bitki Sağlığı Bölümüne de bir ziyarette bulunulmuştur. Burada, Dr. Emine Topuz, Dr. Musa Kırışık, Dr. Selda Çalışkan tarafından 'bitki zararlıları tanısı ve biyolojik mücadelesi' ne ilişkin laboratuvar uygulaması yaptırılmıştır. Öğrencilerimiz teorik derslerde öğrendikleri mesleki bilgiyi bizzat uygulama yaparak pekiştirme imkanı bulmuşlardır.